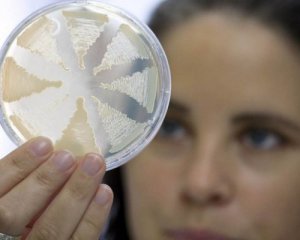

Українців атакує смертельна інфекція
З січня 2018-ку 80 українців потрапили до лікарні з ботулізмом. 7 випадків закінчилися летально.
Фахівці закликають забути про такі продукти, як в'ялена, солона і консервована риба, консерви та м'ясні вироби без термічної обробки, поки не закінчиться літній період, повідомляють у Центрі громадського здоров'я українського МОЗ.
Ботулізм - це важке харчове отруєння, спровоковане продуктами, що містять ботулотоксини. Збудник хвороби розмножується навіть без доступу кисню. Це відбувається, якщо продукти зберігають або перевозять у неправильних температурних умовах.
Лікарі попереджають, що першочерговими ознаками ботулізму є неврологічні розлади - порушення зору (двоїння або туман в очах), невиразність мови, затруднене ковтання, відчуття сухості в роті, м'язова слабкість.
У дітей симптоми ботулізму можуть проявлятися у вигляді апатії, відмови від їжі, тривалого плачу, а також м'язової слабкості.


.jpg)
